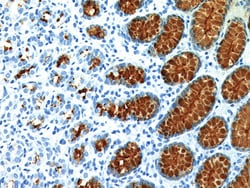
Biocare Medical, LLC Mucin 5AC Antibody - Concentrate, 0.1 ml, Quantity:

Learn More
Biocare Medical, LLC Mucin 5AC Antibody - Concentrate, 0.1 ml


Supplier: Biocare Medical, LLC CM231A

Mucins are high molecular weight glycoproteins with 80% carbohydrate content and the remaining 20% consisting of a protein core. Mucin 5AC antibody (MUC5AC) is defined as a secretory-type mucin and is seen mainly in gastric foveolar cells. A study has suggested that MUC5AC expression is an early event in tumorigenesis. Another study indicates up-regulation of MUC5AC may be associated with carcinogenesis, malignant potential, progression and clinical behaviors in colorectal signet-ring cell carcinoma.
By clicking Submit, you acknowledge that you may be contacted by Fisher Scientific in regards to the feedback you have provided in this form. We will not share your information for any other purposes. All contact information provided shall also be maintained in accordance with our Privacy Policy.